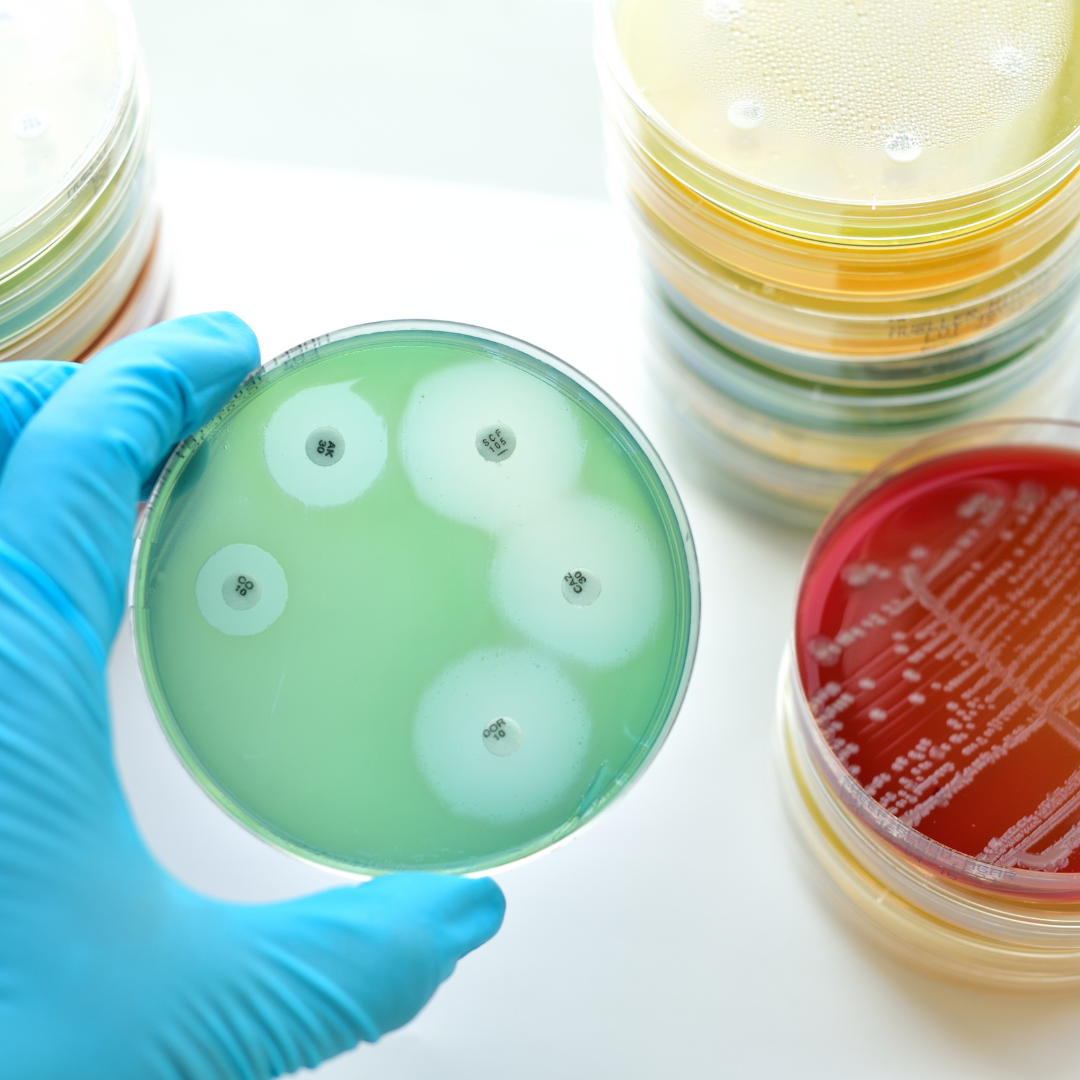

Infectious Diseases
Microbiology involves diagnosing and treating infectious diseases caused by micro-organisms.


About us
Infectious diseases remain a major health challenge, requiring rapid identification, ongoing surveillance, and coordinated responses.
Ampath’s Infectious Diseases division offers a comprehensive range of diagnostics, resources, and expert guidance to support healthcare providers and the broader community. Our services extend beyond laboratory testing to include real-time epidemiological updates and educational materials.
With an extensive A–Z disease index and easy access to guidelines, our goal is to empower healthcare practitioners with the knowledge and tools needed for early detection, accurate diagnosis, and effective treatment.
Infectious Disease Services
Microbiology
A specialized facility where microorganisms such as bacteria, viruses, fungi, and parasites are studied, identified, and tested.

Molecular Biology
A specialized lab where scientists study biological processes at the molecular level, especially involving DNA, RNA, and proteins.

Serology
Combines serology with molecular biology techniques to enhance diagnostic accuracy.
Our Expertise
Our team of microbiologists, molecular biologists, and serologists delivers expert diagnostic services, ensuring accurate and timely results across a wide spectrum of infectious diseases. We support clinicians with specialized knowledge and collaborate closely with public health authorities to monitor disease patterns across the country. Our commitment to clinical excellence includes providing up-to-date information on disease trends, antimicrobial resistance, and infection control practices. Regular alerts and updates keep our clients informed about emerging threats such as M-Pox, Diphtheria outbreaks, and the influenza season.


Key Tests / Services
Ampath offers an extensive menu of infectious disease tests, accessible through our Microbiology, Molecular Biology, and Serology departments. The Microbiology division provides a wide range of culture and sensitivity testing, while Molecular Biology focuses on cutting-edge PCR and sequencing technologies. Our Serology team specializes in antibody detection and immunological profiling. Clients can easily navigate our Infectious Diseases A–Z index, which provides detailed information and links to further resources, including NICD guidelines and educational content such as PathChats. We also offer a dynamic dashboard highlighting provincial viral trends and weekly updates.
Our Technology
We utilize state-of-the-art diagnostic platforms that combine automated testing with advanced molecular techniques. Our laboratory information system enables seamless integration of test results and epidemiological data, ensuring accurate reporting and efficient turnaround times. To enhance accessibility, we are developing a province-specific interactive dashboard, allowing clinicians to view circulating pathogen trends in real time. This system will support informed decision-making and promote proactive patient care.


Why Choose Us
Ampath’s Infectious Diseases service stands out for its depth of expertise, broad diagnostic capabilities, and commitment to continuous education. Our nationwide presence allows for swift testing and reporting across South Africa. We prioritize accessibility, offering clinicians not only diagnostic services but also comprehensive resources, including antibiotic guidelines, local epidemiology reports, PathChats, and infection control publications. By staying ahead of emerging trends and maintaining strong partnerships with healthcare professionals, we ensure that our clients receive the highest standard of care and support.
Additional Information
Our digital tools and resources are designed with clinicians in mind. The Infectious Diseases A–Z directory offers quick access to disease-specific information, while our dashboard provides timely provincial updates on circulating pathogens. Educational materials, such as webinars, podcasts, and lab updates, are readily available, and our marketing banners keep clients informed about new tests, workflow changes, and important healthcare events like World TB Day.

Get in Contact with us

Get in Contact with us

Paternity/Kinship Testing
Ampath Laboratories offers accredited forensic DNA testing to determine biological relationships in both legal and personal contexts. Our analyses are based on validated genetic methodologies and adhere to strict chain of-custody protocols to ensure results are accurate, confidential, and legally admissible when required.
Our relationship testing services are commonly used in the following scenarios:
Paternity testing – to confirm or exclude the biological relationship between a child and an alleged father
Maternity testing – in cases of adoption, surrogacy, or hospital mix-ups
Sibling testing – to assess whether individuals share one or both biological parents
Grand parentage testing – useful when the alleged parent is unavailable for testing
Avuncular testing – to determine a biological relationship through an aunt or uncle
Immigration and citizenship cases – where proof of a biological relationship is required by authorities
Inheritance or estate claims – to establish rightful beneficiaries in legal matters
Personal reassurance – for individuals seeking clarity about their biological relationships without legal proceedings
Testing can be requested by private individuals, legal professionals, or government agencies, and results are typically available within a standard turnaround time under full confidentiality.:




.png)





.png)


.avif)




.avif)




.png)



